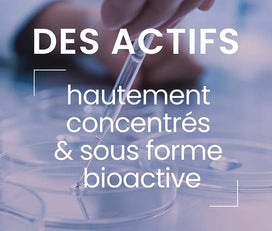

Ça marche !
"Je viens de repasser une commande. Pendant la période de traitement, j’ai vu les bénéfices, sommeil, humeur et énergie. Je recommande à 100%"


15,90€

Quel collagène choisir ?


Voir en détail
81,70€
72,90€


Voir en détail
48,70€
41,90€
Vos besoins
Tous nos complémentsBeauté - Nutricosmétique
Tous nos complémentsImmunité - Vitalité
Tous nos complémentsMinceur - Digestion
Tous nos complémentsSport - Articulations
Tous nos complémentsMétabolisme - Système cardiovasculaire
Tous nos complémentsSanté féminine
Tous nos complémentsSanté masculine
Tous nos compléments
Dynveo, Laboratoire français pionner en nutraceutique pure
Nos actifs
Tous nos complémentsTous nos actifs
Tous nos complémentsLes actifs bio
Tous nos complémentsLes indispensables
Tous nos complémentsLes meilleures ventes
Tous nos complémentsLes nouveautés
Tous nos compléments
Programmes santé
Tous nos complémentsNos programmes santé
Tous nos complémentsNos programmes beauté & bien-être
Tous nos complémentsNos programmes sport
Tous nos compléments
NOUVEAU
-10% dès 2 produits achetés sur le "Métabolisme"
MON PANIER 0
Encore 69€ pour la livraison gratuite
Votre panier est vide
-15% dès maintenant
Rejoignez le Club Dynveo pour 25€/an
-15% sur toute la nutraceutique pendant 1 an
Accès anticipé aux nouveautés et innovations produits
Contenu expert réservé aux membres : conseils, webinaires...
Adhésion valable 1 an sans engagement














Les bienfaits de notre Complexe Ménopause

Soutient l’équilibre et la production des hormones
Contribue à l'équilibre hormonal (gattilier, vitamine B5)
Contribue à la synthèse des hormones stéroïdes (progestérone et œstrogènes) (vitamine B5)
Aide à passer une ménopause confortable
Aide à calmer les bouffées de chaleur (houblon, actée à grappes noires)
Limite les inconforts liés à la transpiration
Soutient le calme, la relaxation et la sérénité
Aide à diminuer l'agitation et l'irritabilité (houblon, actée à grappes noires)
Calme le système nerveux et favorise le sommeil (houblon)
Soutient l’énergie, le cœur et la circulation veineuse
Soutient l’énergie et lutte contre la fatigue (vitamine B5)
Maintient la santé du cœur et aide à maintenir une fonction cardiaque normale (OPC)
Aide à la circulation veineuse et capillaire (OPC)
Soutient les articulations (actée à grappes noires)
Aide à contrôler ou stabiliser le poids corporel (OPC)
Contribue à la santé et la jeunesse de la peau (OPC)
A une action antioxydante et anti-âge (actée à grappes noires, OPC)
Ménopause5

Cible les causes et les conséquences
Une synergie d'actions
Actifs naturels premium
Pureté et sécurité
Pour la formulation de notre complexe Ménopause5, nous avons réalisé de nombreuses recherches scientifiques approfondies sur les actifs qui entrent dans sa composition ainsi que sur la ménopause, ses causes et ses conséquences. Nous voulions vous proposer une solution naturelle globale et pertinente ciblant les causes (fluctuation puis chute des hormones ovariennes), pour une action directe sur les conséquences principales (bouffées de chaleurs, irritabilité…) et secondaires (beauté de la peau, système cardiovasculaire…) de la ménopause. Nous avons cherché à comprendre les mécanismes physiologiques chez les femmes vivant une ménopause inconfortable. Les études scientifiques mettent en lumière l’implication de l’équilibre hormonal, et secondairement de la circulation sanguine dans les déséquilibres, leurs manifestations et leurs conséquences. L’action synergique et globale de notre complexe sur l’ensemble de ces grandes fonctions régulatrices de l’organisme vous offre une réponse directe aux multiples signes associés à la ménopause. En ciblant la dérégulation hormonale, Ménopause5 aide à passer une pré-ménopause et une ménopause calmes et confortables, tout en équilibrant les différentes conséquences physiologiques provoquées par ces dernières.

Les actifs que nous avons sélectionnés sont soutenus par la littérature scientifique pour des actions sur la ménopause et ses conséquences. Pour une efficacité et une assimilation optimales, nos extraits de plantes sont hautement titrés en actifs et nos vitamines sont sous leur forme bioactive.
La ménopause est précédée d’une phase de pré-ménopause qui se caractérise par une baisse des hormones stéroïdiennes, notamment la progestérone, et pouvant engendrer :
Les actifs que nous avons sélectionnés permettent de soutenir la sphère hormonale pendant cette période particulière de fin des menstruations. La vitamine B5 permet de stimuler la synthèse des hormones stéroïdiennes, notamment la progestérone. Le gattilier contribue à réguler la sphère hormonale dans son ensemble et à l’équilibre hormonal féminin pendant la pré-ménopause. De plus, plusieurs études cliniques montrent que le gattilier, titré en agnuside, est efficace pour améliorer le confort du cycle menstruel. Le houblon et l’actée à grappes noires viennent compléter l’action du gattilier en agissant de façon positive sur l’humeur. Les OPC permettent de soutenir la circulation veineuse.
Lors de la pré-ménopause, la circulation est sollicitée avec l’apparition de lourdeurs au niveau des jambes. Ces inconforts s'expliquent par une altération du collagène, composant essentiel du système circulatoire, engendrée par le déséquilibre hormonal.

Les hormones sexuelles agissent sur de nombreux organes, leur déséquilibre lors de la ménopause peut alors favoriser l’apparition d’inconforts et de signes spécifiques à cette période de la vie d’une femme. Les œstrogènes en quantité insuffisante peuvent par exemple engendrer des bouffées de chaleur, des tensions, de l’irritabilité et de la sécheresse cutanée.
Nos actifs permettent de vous aider à passer une ménopause plus calme et confortable. La vitamine B5 stimule la synthèse des hormones féminines telles que les œstrogènes et la progestérone, et le gattilier contribue à l’équilibre hormonal féminin pendant la ménopause. De plus, le houblon Lifenol® a fait l’objet d’études cliniques sur les inconforts liés à la ménopause. Son action sur les bouffées de chaleur et la transpiration a été scientifiquement évaluée. De même, l’actée à grappes noires aide lors des bouffées de chaleur, par une action plus centrale.

La ménopause a de multiples conséquences autres, plus profondes et pérennes, sur l’organisme, notamment sur la circulation sanguine et la beauté de la peau. Nos actifs ont été judicieusement sélectionnés pour permettre également de renforcer ces fonctions physiologiques pouvant avoir besoin de soutien pendant la ménopause.
La vitamine B5 soutient l’énergie tout en diminuant la fatigue. En complémentarité, le houblon favorise l’apaisement et le sommeil, mais a également été évalué pour sa contribution au bon fonctionnement du tractus intestinal. Les OPC, quant à eux, soutiennent le système cardiovasculaire ainsi que la beauté de la peau. Enfin, l’actée à grappes noires est également reconnue pour avoir une action anti-oxydante, anti-âge, et pour soutenir les articulations.
De façon générale, notre complexe agit sur l’équilibre hormonal, physique et émotionnel de la femme ménopausée.

Pour une efficacité et une sécurité optimales, notre formule est pure et 100% vegan. Comme toujours, nous vous garantissons la qualité et la sécurité de notre complexe grâce aux analyses de nos matières premières, qui suivent un plan de contrôle qualité strict. Nos extraits de plantes sont titrés en actifs. La vitamine B5 est 100% pure, sous sa forme bioactive. Notre complément alimentaire est fabriqué dans notre unité de production certifiée ISO 22000, à Teyran (34) et conditionné dans des gélules 100% végétales, sans ajout d’excipients ni d’additifs controversés.

Pour qui ?
Idéal pour les femmes en pré-ménopause souhaitant être accompagnées dans cette transition : inconforts liés au cycle, variations d'humeur, circulation... Parfait pour les femmes ménopausées ou en transition hormonale, sujettes aux bouffées de chaleur, aux sensations de transpiration, à la fatigue, à l'agitation, à l'inconfort articulaire...
Dosage journalier
1 gélule par jour : pour contribuer à l’équilibre des hormones et des différents signes.
Quand ?
Au cours d’un repas pour optimiser l’absorption des actifs.
Durée recommandée
Les études s’étendent généralement sur 8 à 12 semaines. À renouveler après une pause de quelques semaines, en fonction des besoins.
Comment ?
À avaler avec un verre d’eau, au cours d’un repas. Une prise quotidienne régulière maximise l’efficacité.
Ne pas dépasser la dose journalière recommandée. Les compléments alimentaires ne peuvent être utilisés comme substituts d’un régime alimentaire varié. Tenir hors de portée des enfants. Conserver dans un endroit frais et sec.
Ce produit est déconseillé en cas d'antécédents personnels ou familiaux de cancer du sein ou hormonodépendant. Déconseillé en cas de tumeur hypophysaire à prolactine, ou d’antécédents de troubles hypophysaires. Ne pas consommer en cas d'affection biliaire ou hépatique.
Aucune interaction n'est observée entre le produit et d'autres substances.
Notre complexe Ménopause est déconseillé aux femmes enceintes ou allaitantes.
Le complexe Ménopause cible les femmes pré-ménopausées ou ménopausées, et est réservé aux adultes.
Dynveo est fier de vous présenter son complexe Ménopause5, le complément alimentaire idéal pour les femmes ménopausées et pré-ménopausées dont les inconforts affectent leur qualité de vie au quotidien. Composé d’actifs naturels tels que des plantes titrées et des vitamines sous leur forme bioactive, ce complexe formulé sur la base d’études scientifiques répond de façon synergique et globale aux inconforts liés à la pré-ménopause ainsi qu’à la ménopause.
| Informations nutritionnelles | Pour 1 gélule végétale | VNR* (en %) |
|---|---|---|
| Extrait sec de Pépins de raisin (Vitis vinifera), standardisé à 96% en polyphénols dont 75% min. en procyanidine (OPC) | 150 mg | |
| Extrait sec de Gattilier (Vitex agnus-castus), standardisé à 0,5% min. en agnuside | 96 mg | |
| Extrait sec de Houblon Lifenol® (Humulus lupulus L.) standardisé à 0,2% en 8-prénylnaringénine | 85 mg | |
| Vitamine B5 (pantothénate de calcium) | 6,8 mg | 114% |
| Extrait sec d’Actée à grappes noires (Cimicifuga racemosa) standardisé à 5% min. en saponines | 6,5 mg | |
| * VNR : Valeurs Nutritionnelles de Référence |
Tunique d’origine végétale (pullulan), fibres d’acacia.
Lifenol® est une marque déposée de Givaudan SA.
Overall rating: 4.0 / 5 from 16 reviews.
Review topics: [].
"Je viens de repasser une commande. Pendant la période de traitement, j’ai vu les bénéfices, sommeil, humeur et énergie. Je recommande à 100%"
— Sophie B. (5/5)
"J’utilise ce complexe depuis de nombreux mois et j’en suis très satisfaite"
— jeshabel s. (5/5)
"Ne convient pas à mon épouse."
— Philippe M. (1/5)
"Pour le moment pas de différence"
— Marion C. (2/5)
"Ma femme en est contente"
— Christophe K. (4/5)
"Ce produit a été très efficace pour les sécheresses vaginales."
— Odile C. (5/5)
"Très bon complexe. a agit en quelques jours sur mes bouffées de chaleur (moderees) et irritabilite"
— ghyslaine P. (5/5)
"Très efficace je n’ai pratiquement plus de bouffées de chaleur quel confort ! J’apprécie le confort que m’a apporté ce complexe ménopause !"
— Patricia L. (5/5)
"Malheureusement il n’agit plus comme au début du traitement."
— Valerie D. (3/5)
"Produit inefficace"
— Aline (1/5)
Ménopause5 est un complexe naturel répondant aux inconforts associés à la ménopause. Ce phénomène physiologique naturel se traduit par l’arrêt des menstruations, confirmé après 12 mois consécutifs d'aménorrhée (absence de règles), et la perte de la fonction de reproduction. Lorsque le stock de follicules ovariens est naturellement épuisé, les hormones œstrogènes et progestérone qui contrôlent le cycle féminin sont au plus bas, mais elles continuent d’être produites en petite quantité. La ménopause est précédée d’une période de variabilité dans les cycles menstruels connue sous le nom de pré-ménopause (ou péri-ménopause), elle survient souvent chez les femmes entre 45 et 55 ans. La ménopause est responsable de différents inconforts qui, dans 20 à 25% des cas selon l’INSERM, dégradent la qualité de vie d’une femme. Les inconforts associés apparaissent progressivement dès la pré-ménopause et entraînent des conséquences pérennes dans le corps de la femme ménopausée. L’équilibre hormonal en est le principal acteur. En effet, les hormones ovariennes œstrogènes et progestérone sont impliquées dans de nombreuses fonctions physiologiques telles que la thermorégulation, l’humeur et le sommeil, mais aussi l’hydratation de la peau, la santé osseuse et cardiovasculaire.
Composé de 5 actifs naturels, notre complexe Ménopause5 cible préférentiellement la régulation hormonale, responsable en grande partie des inconforts rendant la ménopause désagréable pour la plupart des femmes. Il convient à toutes les femmes pré-ménopausées ou ménopausées, gênées par des inconforts jour et nuit, afin de retrouver une pré-ménopause ou une ménopause calme et confortable au quotidien.
On ne “remplace” pas les hormones naturellement comme le ferait un traitement hormonal. En revanche, certains compléments peuvent accompagner la transition ménopausique en ciblant ses manifestations les plus fréquentes : bouffées de chaleur, agitation, variations d’humeur, sommeil ou inconfort circulatoire. L’approche la plus juste consiste donc à soutenir l’équilibre féminin et la qualité de vie, sans avoir un effet hormonal identique à un THM.
Un Complexe Ménopause en gélules peut être intéressant pour accompagner les bouffées de chaleur lorsqu’il associe des actifs ciblant le confort hormonal et vasculaire. Chez Dynveo, la formule réunit notamment houblon, actée à grappes noires, gattilier, OPC de pépins de raisin et vitamine B5, avec un positionnement orienté bouffées, transpiration, agitation et inconforts de la transition ménopausique.
Il peut constituer un soutien lorsque les sueurs nocturnes s’intègrent au tableau classique de la ménopause. L’objectif d’une formule complète n’est pas d’agir comme un médicament, mais d’accompagner plus globalement les déséquilibres hormonaux, les sensations de transpiration et l’inconfort jour/nuit, avec des actifs choisis pour leur complémentarité.
Oui, indirectement, lorsqu’il aide à mieux vivre les déséquilibres de la ménopause. Dynveo positionne sa formule sur l’agitation, les variations d’humeur et le confort global de cette période. Le houblon et l’actée à grappes noires sont notamment mis en avant sur le site pour accompagner l’irritabilité et contribuer à une ménopause plus calme et confortable, ce qui peut aussi favoriser un meilleur sommeil.
Un bon Complexe Ménopause mise sur des actifs complémentaires, bien dosés et standardisés : plantes ciblant le confort hormonal et les bouffées de chaleur, actifs vasculaires pour la circulation, et cofacteurs comme la vitamine B5. La formule Dynveo associe précisément extraits titrés de pépins de raisin, gattilier, houblon Lifenol®, actée à grappes noires et vitamine B5, avec une logique de synergie plutôt qu’un simple empilement d’ingrédients.
Il peut contribuer au bien-être féminin au sens large en aidant à mieux vivre certains inconforts de la ménopause, comme la fatigue, l’agitation, les bouffées de chaleur ou la baisse de confort quotidien. En revanche, pour la libido, il est préférable de rester mesuré, l’amélioration peut être indirecte via un meilleur équilibre général, mais ce n’est pas une promesse automatique ni le positionnement principal de la formule.
L’essentiel est surtout la régularité. La formule Dynveo est prévue à raison d’1 gélule par jour, dans une logique d’accompagnement quotidien de la pré-ménopause et de la ménopause. Comme ce type de complément agit sur des mécanismes progressifs, une prise régulière, intégrée à la routine, est généralement plus pertinente qu’une utilisation ponctuelle.
Les premiers ressentis varient selon les femmes, l’intensité des symptômes et le contexte hormonal. En pratique, on raisonne plutôt en semaines qu’en quelques jours, car il s’agit d’un accompagnement de terrain. L’important est d’évaluer la réponse de façon réaliste et régulière, sans attendre un effet immédiat comparable à celui d’un traitement hormonal.
Une prise continue peut s’envisager si elle reste cohérente avec le besoin et les précautions d’emploi. Cela dit, comme pour beaucoup de compléments ciblant un terrain hormonal, il est souvent pertinent de faire le point après plusieurs semaines d’utilisation. Il faut aussi tenir compte des contre-indications indiquées par le fabricant, notamment en cas d’antécédents de cancer hormonodépendant, de troubles hypophysaires ou d’atteinte hépatobiliaire.
Les besoins varient selon le profil, mais certaines vitamines et certains minéraux sont particulièrement intéressants à surveiller à cette période. Dynveo met notamment en avant la vitamine B5 dans son Complexe Ménopause, ainsi que, plus largement dans son approche hormonale, la vitamine D3, le magnésium et certaines vitamines du groupe B comme soutiens nutritionnels utiles selon le contexte.
La prudence est recommandée. Les troubles thyroïdiens peuvent mimer certains symptômes de la ménopause, et certains compléments “ménopause” ou phytoestrogéniques peuvent nécessiter un avis médical, surtout en cas d’hypothyroïdie traitée. Les autorités spécialisées indiquent que ces produits n’affectent pas forcément la fonction thyroïdienne normale, mais ils peuvent parfois influencer l’ajustement d’un traitement thyroïdien ; mieux vaut donc demander l’avis du médecin ou du pharmacien avant usage.
Certaines associations de compléments peuvent être intéressantes avec un Complexe Ménopause, selon les besoins de la période, notamment en matière de vitalité, de confort féminin et de soutien global de l’organisme.
ANALYSES SYSTÉMATIQUES
TRANSPARENCE TOTALE
TRAÇABILITÉ COMPLÈTE
LABELS TECHNIQUES RECONNUS